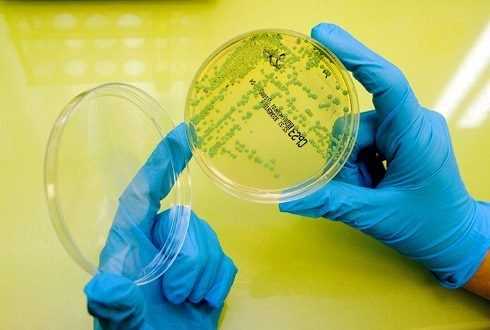

Лекарства от цистита — поиск лекарств и наличие в аптеках
Циститом называют воспалительный процесс, развившийся в стенке мочевого пузыря. Вызывается он, в основном, бактериями, проникшими в орган депонирования мочи из промежности, поднявшись по мочеиспускательному каналу. Опасен цистит тем, что бактерии из мочевого пузыря могут добраться и до почечной ткани, спровоцировав ее тяжелое воспаление. Могут вызвать они и острую задержку мочи, тогда сходить в туалет можно будет только с врачебной помощью.
Чтобы этого не случилось, нужен список лекарств от цистита. В него включают различные препараты, направленные как на устранение причины патологии, на «выключение» механизма, поддерживающего воспаление, так и на профилактику осложнений.
Какие лекарства принимают при цистите
Перечень лекарств от цистита включает в себя такие основные группы:
Антибиотики;
Антисептические средства;
Противовирусные или противогрибковые препараты;
Спазмолитики;
Противовоспалительные препараты;
Фитотерапия;
Пробиотики;
Препараты, приводящие в тонус иммунную защиту.
Что подразумевается под каждым из терминов, какие примеры подобных лекарств и механизм их действия, рассмотрим подробнее.
Антибактериальная терапия
Антибиотик – это лекарство от цистита, которое уничтожает бактерии, являющиеся причиной данного заболевания. При остром цистите лечение начинается с назначения антибактериального препарата широкого спектра действия, способного справиться с бактериями различных свойств. Через 3-5 суток, когда придут результаты бактериологического исследования мочи, можно подобрать антибактериальное средство более узкой направленности, к которому конкретно будет чувствительна бактерия-возбудитель. Хронический цистит нужно лечить только с учетом микробиологических данных.
Наиболее хорошо цистит поддается терапии антибиотиками таких групп:
Фторхинолоны. Они разрушают бактериальные клетки и блокируют ферменты. К ним относят: Норфлоксацин, Левофлоксацин, Ципрофлоксацин, Спарфло.
Производные фосфоновой кислоты, оказывающей бактерицидное действие: Монурал.
Пенициллиновые производные, блокирующие фермент, благодаря которому микроб мог синтезировать свою клеточную стенку: Тикарциллин, Аугментин, Ампиокс.
Цефалоспориновый ряд. Это, в основном, инъекционные препараты, действие которых направлено на повреждение клеточной стенки бактерий. К таблетированным препаратам-цефалоспоринам, применяющихся для лечения цистита, относятся: Супракс, Цедекс. Тяжелые же и осложненные формы заболевания лечатся цефалоспоринами в виде уколов: Цефотаксимом, Цефтриаксоном, Цефтазидимом, Цефоперазоном.
Уроантисептики
Это препараты, проявляющие не только антибактериальную, но и противопротозойную, и противогрибковую, и отчасти противовирусную активность. Устойчивость микробов к ним, в отличие от таковой для антибиотиков, практически не вырабатывается. Все эти лекарства выводятся с мочой.
Для терапии острого бактериального цистита эффективно применять комбинацию из 1 антисептика и 1 антибиотика. Длительность курса – не менее 5 дней.
Для терапии цистита доказали свою эффективность такие антисептики:
Противогрибковые средства
Их назначают или в случае грибкового цистита, или для профилактики присоединения грибковой флоры, если требуется более 5 дней лечения антибиотиками. Здесь применяются такие препараты как Флуконазол, Вориконазол или Кетоконазол.
Противовирусные средства
Данные препараты применяются в лечении циститов, имеющих вирусное происхождение. Это:
Виферон;
Бетаферон;
Циклоферон;
Реальдирон.
Спазмолитические средства
Препараты этой группы призваны расслабить гладкие мышцы самого мочевого пузыря и выхода из него. Это облегчает боль и устраняет застой инфицированной мочи, который образуется при цистите из-за болевого синдрома.
Такие спазмолитики как Но-шпа, Бускопан в таблетках или инъекционный Папаверина гидрохлорид входят в обязательный список лекарства от цистита.
Противовоспалительные и обезболивающие средства
Боль, сопровождающую мочеиспускание, при цистите терпеть нельзя. Это означает, что акт похода в туалет останется незавершенным, в мочевом пузыре останется большее, чем допустимо, количество мочи. Тогда последняя может заброситься по мочеточникам и инфицировать и их, и почки. Поэтому боль нужно устранять. Для этого применяются нестероидные противовоспалительные препараты: Диклофенак, Ибупрофен, Нимесил.
Фитотерапия
Относительно универсальным средством, обладающим противовоспалительным, спазмолитическим и антисептическим свойствами, называют лекарство от цистита на растительной основе – препарат Канефрон на основе травы золототысячника, листьев розмарина, корня любистка. Его выпускают как в виде капель на спиртовой основе, так и в форме капсул.
Не менее эффективен препарат Цистон. Это таблетки, совмещающие полезные свойства более десяти растений. В комплексе они обеспечивают противомикробное, спазмолитическое, обезболивающее, противовоспалительное, мочегонное действие, способны растворять мочевые камни.
Монурель. Это препарат на основе экстракта клюквы. Обладает антисептическим, мочегонным и противовоспалительным действием. Это природный антибиотик, разрешенный для приема детям и беременным, сокращает сроки лечения и профилактирует возникновение рецидива.
Пробиотики
Это препараты, задача которых – нормализовать состав микрофлоры кишечника, откуда в мочевыводящие пути попадают патогенные микробы, а также самих мочевыводящих путей. Одни из них, например, Энтерожермина, применяют во время проведения антибиотикотерапии. После окончания приема антибиотиков и антисептиков применяют: Бифидумбактерин, Бифиформ, Хилак, Линекс, РиоФлора Баланс.
Иммуномодуляторы
Для активации защитных сил мочевыводящей системы применяются такие средства, как:
Ликопид;
Уро-Ваксом;
Виферон.
Эти средства помогают выработать адекватный иммунный ответ на внедрение инфекционного агента, провести профилактику рецидива цистита.
Препараты по теме Посмотреть все препараты
vapteke.ru
Лекарства от цистита у женщин
Многие женщины хоть раз в жизни сталкивались с циститом. Это заболевание приносит множество неудобств и болевых ощущений. Чтобы избавиться от цистита необходимо пройти курс лечения, состоящий из лекарственных препаратов. Только специализированное лечение из комплекса средств обеспечивает полное избавление от болезни.
О заболевании
Цистит является воспалительным заболеванием, поражающим мочевой пузырь.
Различают несколько видов цистита:
- первичный/вторичный;
- острый/хронический;
- инфекционный/неинфекционный.
Симптомами этой болезни считаются:
- Боли по окончании процесса мочеиспускания: характеризуются острым режущим ощущением.
- Частые позывы для посещения туалета: мочеиспускание может происходить вплоть до нескольких раз в течение 10 минут.
- Невозможность полностью опустошить мочевой пузырь: испражнения выходят очень маленькими порциями, по каплям.
- Постоянное ощущение наполненности мочевого пузыря.
- Боли внизу живота: характер ноющий.
- В острой форме наблюдаются кровяные пятна в моче.
Такие неприятные ощущения всегда указывают на наличие цистита. Избавиться от них можно лишь медикаментозным путем. Откладывание лечения приводит к ухудшению ситуации. Точное диагностирование заболевания происходит за счет анализа мочи по Нечипоренко и УЗИ мочеполовых органов. После лечения проводится повторный анализ.
Наиболее частыми причинами цистита считается переохлаждение нижней части тела, преимущественно тазовой области. Банальное поедание острой и жирной пищи, сидячий образ жизни, недостаток гигиены также могут спровоцировать заболевание. Приводят к циститу и травмы слизистой оболочки мочевого пузыря, хронические заболевания мочеполовой системы, инфекционные очаги в организме, повышенное наличие кишечной палочки.
Лекарства от цистита у женщин перечень

Благодаря современным препаратам возможно быстрое излечение от цистита. Чем лечить цистит у женщин? Лекарства, которые назначает врач составляют комплексную терапию, состоящую из антибиотиков, препаратов от воспаления, натуральных средств. Рассмотрим наиболее популярные и действенные аптечные лекарства.
Антибиотики и противовоспалительные лекарства
Препараты антибиотики направлены на подавление и уничтожение болезнетворных бактерий. Именно лекарства данной группы являются основой лечения цистита. Необходимы в терапии цистита также противовоспалительные лекарства, которые нормализуют состояние мочевого пузыря.
Фурамаг
Противомикробный препарат нового поколения. Основа действующего вещества ― фуразидин. Препарат относится к категории нитрофуранов. В отличие от предшествующих поколений средств: Фурадонин, Фурагин, в меньшей степени проявляет побочные эффекты. Прием препарата производится внутрь после еды. Дозировка: 50‒100 мг 3 раза в течение суток. Следует запивать большим количеством теплой воды. Лечение составляет 10 дней.
Монурал
Антибиотик широкого спектра действия. Действующее вещество: фосфомицина трометамол. Имеет приятный мандариновый вкус. Прием производится внутрь. Разовая дозировка составляет 3 г, то есть один пакетик средства. Продолжительность приема 5‒7 суток.
Флемоксин Солютаб
Препарат антибиотик пенициллиновой группы. В качестве активного вещества выступает амоксициллин. Препарат принимается вне зависимости от приема пищи. Удобство характеризуется способом приема. Возможно принимать таблетки не разжевывая внутрь, а также растворять их в воде до получения суспензии. Благодаря быстрому растворению препарат оказывает скоростное влияние, отличается хорошей всасываемостью в организме. Дозировка: 2 раза в день по 500‒750 мг или 3 раза в сутки по 375‒500 мг. Курс лечения 5‒7 дней.
Норбактин
Противомикробное средство с действующим веществом норфлоксацин в составе. Прием препарата строго натощак с выпиванием большого количества жидкости. Дозирование: 400 мг по 2 раза в день в течение 3‒7 дней.
Палин
Антибиотический препарат ряда хинолонов. В составе Палина наблюдается действующее вещество пепимидовой кислоты тригидрат. Принимать необходимо через каждые 12 часов, то есть утром и вечером. Дозировка 200 мг на один прием. Выпивать внутрь перед едой.
Лекарства от цистита для женщин на натуральной основе

Обязательным условием лечения цистита является прием натуральных препаратов. Многие растительные и бактериальные комплексы способны в кратчайшие сроки устранить неприятные ощущения от заболевания.
Уро-Ваксом
Современный действенный препарат направленный на устранение микроорганизмов, вызывающих цистит. Активное вещество в составе ― это лиофилизированный лизат бактерий Escherichia coli. В результате применения повышается местный иммунитет, который борется с болезнетворными бактериями. Плюсом можно считать удобное применение. Одна капсула выпивается с утра натощак. По плану комплексного лечения прием длится 1 месяц, для профилактики и предотвращения рецидивов курс 3 месяца.
Фитолизин
Паста, состоящая исключительно из растительных компонентов. В составе: экстракты золотарника, хвоща, горца птичьего, пырея, шелухи лука, пажитника, любистока, петрушки, березы, масло шалфея, мяты и сосны. Благодаря этому достигается диуретический, обезболивающий и литолитический эффект. Помогает быстро устранить болевые симптомы цистита. Улучшение заметно на 2 день приема. Необходимо учесть, что у препарата очень специфический вкус, который подходит не всем. Для употребления готовят раствор из сладкой теплой воды с чайной ложкой препарата. Выпивать суспензию стоит 3–4 раза в день в течение месяца.
Цистон
Фитотаблетки, обладающие литолитическим, диуретическим и противовоспалительным эффектом. Состав: Экстракты двуплодника стебелькового, сыти пленчатой, вернонии пепельной, соломоцвета шероховатого, камнеломки язычковой, оносмы прицветковой, марены сердцелистной, а также порошка мумие и силиката извести, смеси базилика, мимозы, павонии, тикового дерева, хвоща, якорцев, конских бобов. Применяются по 2 таблетки 2 раза в сутки, до окончания комплексного лечения.
Канефрон
Драже и капли на основе растительного сырья из травы золотысячника, листьев розмарина и корней любистока. Оказывает мочегонное и противовоспалительное действие, что быстро выводит бактерии из организма. Принимать нужно по 2 драже или 50 капель препарата 3 раза в сутки. Длительность курса определяет лечащий врач.
Монурель
Не стоит путать растительный препарат Монурель с антибиотиком Монурал. Лекарство оказывает влияние на организм посредством препятствия попадания в мочевой пузырь вредных микроорганизмов, повышает защитные свойства организма в целом. Состав основан на экстракте плодов клюквы и аскорбиновой кислоте. Следует выпивать 1 таблетку в день перед сном после опустошения мочевого пузыря. Средняя длительность курса 1 месяц.
Препараты от цистита при беременности

Период беременности часто сопровождается циститом. При этом могут оказаться под запретом популярные действенные препараты.
Лекарства при цистите у женщин — список для беременных:
Эти препараты являются наиболее безопасными для применения в данный период.
Цистит у женщин нуждается в срочном лечении специально разработанными препаратами. Именно они способны в кратчайшие сроки устранить причины заболевания. При самолечении возможны серьезные осложнения. Поэтому при появлении первых признаков необходимо показаться врачу урологу.
filzor.ru
лечение, что пить, список препаратов
Большинство людей интересуется, какое поможет лекарство от цистита? Данное заболевание характеризуется воспалением мочевого пузыря, которое сопровождается болевыми ощущениями в области живота и жжением при мочеиспускании. Лечение цистита может осуществляться дома, но при условии правильно подобранного профильным специалистом терапевтического курса. Назначают больному противомикробное средство, антибиотики, таблетки для устранения болезненной симптоматики, а также при необходимости иммуностимуляторы.
Важность лечения
Частые заболевания мочеполовой системы у взрослых и детей — цистит и уретрит. Однако было замечено, что преобладает появление цистита у женщин, нежели у мужчин. Но кто бы подвержен этому недугу не был, принимать лечебные меры следует незамедлительно. Отсутствие своевременного лечения при уретрите и цистите опасно развитием хронической формы этих заболеваний. Если не принимать никакие препараты при воспалении мочевого пузыря, то может развиться осложнение в виде пиелонефрита. Если не лечить цистит, то женщинам это опасно возникновением различных воспалительных заболеваний, например, эндометрита, вульвовагинита, а мужчинам отсутствие должной терапии мочеполового органа грозит появлением везикулита или простатита.
Если отсутствует медикаментозное лечение цистита, то вполне вероятно, что при лабораторном исследовании мочи, в ней может быть замечена кровь. В медицине кровь в моче определяют, как гематурия. Помимо этого, если при диагностировании заболевания мочевика не были использованы никакие лекарственные средства, то больному грозит диагноз «интерстициальный цистит», который характеризуется воспалением мышечного слоя пузыря с его дальнейшей дисфункцией. Этих осложнений можно избежать, если своевременно начать лечить воспаление органа мочевыделительной системы. Поэтому наблюдая симптоматику описываемого недуга, больному в первую очередь следует обратиться к врачу и после подтверждения диагноза начать пить медикаменты, которые ему выписали.
Вернуться к оглавлениюСимптоматика
Распространенные недуги мочеполовой системы — уретрит и цистит, они имеют много сходств, но путать их не стоит. При цистите у женщин отмечается:
- боль в области живота;
- специфический запах мочи;
- помутнение и примеси в моче.
Симптомы уретрита у женщин:
- выделения из мочеиспускательного канала;
- отклонения от нормы в анализах мочи;
- воспалительный процесс во влагалище.
При уретрите и цистите больные одинаково могут ощущать дискомфорт и жжение при мочеиспускании. Однако это два совершенно разных заболевания: цистит определяется как воспаление мочевого пузыря, а уретрит — как воспаление в уретре. Плюс ко всему отличается один недуг от другого еще тем, что при воспаленном пузыре присутствуют сильные позывы к мочеиспусканию даже в ночное время суток, чего не наблюдается при уретрите. Появляется зачастую цистит у женщин, а уретрит вне зависимости от пола.
Вернуться к оглавлениюКакие используют лекарства для лечения цистита?
Для лечения цистита и уретрита медики в большинстве случаев назначают антибиотики. Врачом учитываются тяжесть протекания недуга, противопоказания к медпрепаратам, подбирается индивидуальная дозировка и длительность терапевтического курса. Так как при воспалении мочевика присутствуют воспалительные процессы, боли, то больному потребуется прием противовоспалительных и обезболивающих лекарственных средств.
Вернуться к оглавлениюАнтибиотики
По мнению профильных специалистов против воспаления мочевого пузыря помогают антибиотики (уроантисептики). Их современные названия следующие:
- «Нолицин». Применяют от цистита в борьбе с микробами по 1-й таблетке дважды в день на протяжении 5—6-ти суток. При обострении хронического заболевания мочевика принимают в такой же дозировке, но в течение 6—8 недель.
- «Нитроксолин». Дешевое лекарство для лечения цистита можно приобрести в аптеках без рецепта врача. Прием препарата от мочевого пузыря следует совершать в процессе трапезы 3—4 раза в сутки по 0,05—0,1 г.
- «Монурал». Зачастую выписывают это лекарство от цистита, так как оно действует в отношении практически всех патогенных микроорганизмов, провоцирующих развитие заболеваний системы мочевыделения. Известен «Монурал» наименьшими побочными эффектами и противопоказаниями, поэтому применять его можно даже беременным и маленьким детям. При этом нужно выпить пакетик с лекарством за один прием раз в день и этого будет достаточно для решения проблемы.
Противовоспалительные средства
Обязательно против цистита нужны таблетки, которые относятся к группе нестероидных противовоспалительных лекарственных препаратов. Они снижают интенсивность воспалительного процесса, чем облегчают протекание болезни. К таковым относятся: «Нурофен», «Диклофенак», «Индометацин». От простуды мочевого пузыря хорошо помогает «Ламизил». Этот противовирусный медикамент эффективно борется с грибковыми микроорганизмами, которые служат развитию воспаления в органах мочевыделительной системы.
Вернуться к оглавлениюЛекарства для купирования болезненных ощущений
Какими медикаментами можно помочь при сильных болях, сопровождающих процесс воспаления мочевого пузыря? Медики рекомендуют при цистите попить лекарственные средства, которые быстро снимают спазмы мускулатуры мочевого пузыря и тем самым купируют боли. К таковым относятся:
- «Но-шпа»;
- «Папаверин»;
- «Дротаверин».
Лекарства для иммуностимуляции
Считается, что развитие симптомов воспаления мочевого пузыря может указывать на ослабленный иммунитет, поэтому при лечении цистита зачастую назначают лекарственные средства, которые направлены на повышение иммунной системы человека. Рекомендуется прием препарата «Метилурацил», который является интенсивным стимулятором роста и регенерации нормальной структуры тканей. Кроме этого, можно пить при цистите для повышения защитных функций организма медикаменты «Генферон» и «Циклоферон». Стоит учитывать, что применяя лекарства от цистита, можно ухудшить состояние микрофлоры, поэтому в профилактических целях развития рецидива недуга, после пройденного терапевтического курса следует пропить лактобактерии и бифидобактерии.
Вернуться к оглавлениюДругие фармацевтические средства
Канефрон — растительный препарат.Против воспалительного процесса в мочевом пузыре назначаются фитопрепараты. Наиболее эффективное и относительно недорогое лекарство, применяемое в качестве вспомогательного средства при антибактериальной терапии — «Цистон», в составе которого содержится более 10-ти растительных компонентов. Пить капсулы следует за 30 минут до трапезы по две штуки в день. Не менее действенным медикаментом на растительной основе является «Канефрон». Он применяется от цистита, так как обладает мочегонным и антибактериальным действием. Для терапии мочевого пузыря современная медицина предлагает таблетки «Монурель», которые состоят из экстракта клюквы, способного подавлять негативное действие микробов.
Используют от цистита довольно популярное лекарство «Стрептоцид», которое обладает сильнейшим противомикробным действием. Однако применять его разрешается не всем. Противопоказан «Стрептоцид» больным с заболеваниями почек, печени, а также при беременности и грудном вскармливании. При воспаленном пузыре назначается данный медикамент по 2-е таблетки 3 раза в сутки на протяжении 5-ти дней.
Вернуться к оглавлениюПопулярный список препаратов
Для терапии воспалительного процесса в мочевом пузыре существует множество лекарственных средств и, помимо вышеперечисленных, больными используются следующие медпрепараты:
- «Норфлоксацин»;
- «Энтерофурил»;
- «Фурадонин»;
- «Фурагин»;
- «Фурамаг»;
- «Рулид»;
- «Нефиграмон».
Народные лекарства
Лечение цистита с помощью альтернативной медицины основано на употреблении народных средств. Средства из растительных компонентов применяются на протяжении длительного времени. Эффективным лекарством, которое предлагают целители, считается отвар из травы ортосифона. Следует заварить 3 г растения в стакане кипятка и настоять 20 минут, профильтровать и принимать по 100 мл дважды в сутки. Это средство вылечит не только мочевой пузырь, но и исцелит почки. Кроме этого, для терапии используются различные сборы из ромашки, аира, зверобоя, полевого хвоща и подорожника.
etopochki.ru
Таблетки от цистита
Цистит – воспаление мочевого пузыря. Среди типичных проявлений – болезненные ощущения внизу мочевого пузыря, боль по ходу мочеиспускательного канала (уретры) при акте мочеиспускания. Само мочеиспускание частое, маленькими порциями.
Основной причиной циститов является инфекция, которая может проникать в пузырь нисходящим путем из почек и почечных лоханок.
Восходящая инфекция заносится в мочевой пузырь из уретры при ее воспалении, а также при передаче заболеваний половым путем.
Учитывая, что уретра женщин намного короче, чем у мужчин, женщины более подвержены циститу. В редких случаях к циститу приводят аллергические реакции, обменные нарушения, травмы и опухоли мочевого пузыря.
Основные принципы лечения
Инфекционные возбудители цистита в основном представлены бактериями и простейшими. Среди них – кишечная палочка, стафилококки, стрептококки, протей. Некоторые бактерии и простейшие (гонококки, трихомонады, микобактерии туберкулеза) вызывают специфические виды воспалений мочевого пузыря.
Из этого следует, что основным направлением лечения циститов является антибактериальная терапия с помощью специальных препаратов-уросептиков.
Основные принципы лечения
В роли уросептиков могут выступать как специфические препараты, использующиеся только лишь для лечения инфекций мочевыводящих путей, так и другие средства из группы антибиотиков, применяемые при многих других видах инфекционных процессов.
Данные средства, вне зависимости от групповой принадлежности, должны обладать следующими свойствами:
- Иметь широкий спектр действия – быть эффективными в отношении многих видов инфекций
- В таблетированной форме быть устойчивыми к действию желудочного сока;
- Выводиться почками в неизмененном виде
- Не оказывать токсического действия на почки
- Обладать коротким периодом полувыведения, чтобы в моче за короткий промежуток времени создавалась оптимальная концентрация препарата.
Уросептики относятся к нескольким группам, среди которых:
- Производные нитрофурана
- Производные фосфоновой кислоты
- Хинолоны и фторхинолоны
- Оксихинолины
- Травяные препараты.

Таблетки от цистита
Использованием одних лишь уросептиков не ограничивается комплексное лечение циститов. Необходимо назначать:
- противовоспалительные (Мовалис, Пироксикам),
- общеукрепляющие средства,
- иммуностимуляторы (Пентоксил, Метилурацил, Левамизол),
- витаминно-минеральные соединения.
Эти средства принимаются не только внутрь, но и в виде инъекций. Кроме того, при циститах проводится местное лечение путем т.н. инсталляций (или инстилляций) мочевого пузыря.
В ходе инсталляций через катетер вводятся растворы различные препараты (Декасан, Колларгол, Фурацилин, Димексид, Калия перманганат). Эти препараты на местном уровне оказывают антимикробное и противовоспалительное действие, и тем самым увеличивают эффект таблетированных уросептиков.
Препараты
К наиболее действенным уросептикам относятся:
Монурал
Действующее вещество – Фосфомицин, являющийся производным фосфоновой кислоты. Препарат выпускается в виде растворимых гранул. Пакетик с гранулами растворяется в трети стакана воды.
Перед приемом необходимо опорожнить мочевой пузырь.
Побочные эффекты: аллергическая кожная сыпь, изжога, тошнота, диарея.
Среди противопоказаний: почечная недостаточность, непереносимость Фосфомицина, возраст до 5 лет.
Нолицин
Таблетки с действующим веществом Норфлоксацином. Это довольно мощный антибиотик группы фторхинолонов с широким спектром действия. Поэтому Нолицин зачастую является препаратом выбора при цистите.
Побочные эффекты: головная боль, головокружение, расстройство сна, боль в животе, пищеварительные расстройства.
Препарат не назначают беременным, детям, при тяжелых поражениях печени, почек, а также при острых и хронических нарушениях кровообращения.
Фурагин.
Производное нитрофурана. Таблетки для приема внутрь.
Побочные действия – головная боль, головокружение, тошнота, боли в животе.
Противопоказания: возраст до 7 лет, беременность, индивидуальная непереносимость, хронические заболевания печени и почек.
Фурадонин
Также производное нитрофурана. Таблетки.
Побочные действия и противопоказания аналогичны таковым у Фурагина.
Нитроксолин (5 НОК)

Нитроксолин (5 НОК)
Относится к оксихинолиновым производным.
Препарат выпускается в виде таблеток и назначается не только при циститах, но и при воспалении других отделов мочевыводящей системы – при пиелонефритах, уретритах.
В большинстве случаев Нитроксолин хорошо переносится.
В редких случаях возможна головная боль, головокружение, пищеварительные расстройства.
Противопоказания – индивидуальная непереносимость к препарату.
Среди других антимикробных препаратов, используемых при циститах:
Хинолоны и фторхинолоны:
- Оксолиновая кислота
- Ципрофлоксацин
- Левофлоксацин
- Офлоксацин.
Производные нитрофурана:
- Нитрофурал
- Нифурател
- Нифуртоинол.
Производные нафтиридина:
- Неграм
- Невиграмон
- Налидиксовая кислота.
Бисептол, Сульфадимезин, как и другие лекарства-сульфаниламиды, в настоящее время вообще не применяются. Не назначают их и при циститах, хотя раньше они активно использовались при этом заболевании.
Фторхинолоны, являясь препаратами нового поколения, являются самыми мощными при циститах. В ряде случаев их можно комбинировать с уросептиками других групп.
Наряду с этими лекарствами при циститах широко используются травы, ягоды (толокнянка, клюква, брусника), а также лекарства, изготовленные на основе натурального растительного сырья – Уропрофит, Канефрон, Урофлукс, Цистон. Но применять эти средства можно лишь в комбинации с синтетическими уросептиками.
farmamir.ru